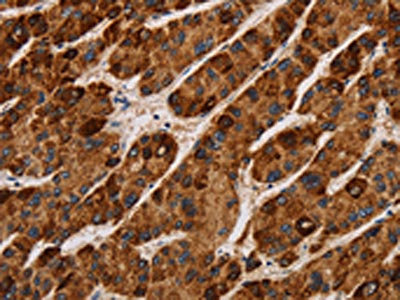

IL17RA Antibody
-
中文名稱:IL17RA兔多克隆抗體
-
貨號:CSB-PA703502
-
規(guī)格:¥1100
-
圖片:
-
The image on the left is immunohistochemistry of paraffin-embedded Human liver cancer tissue using CSB-PA703502(IL17RA Antibody) at dilution 1/40, on the right is treated with synthetic peptide. (Original magnification: ×200)
-
The image on the left is immunohistochemistry of paraffin-embedded Human brain tissue using CSB-PA703502(IL17RA Antibody) at dilution 1/40, on the right is treated with synthetic peptide. (Original magnification: ×200)
-
Gel: 6%SDS-PAGE, Lysate: 40 μg, Lane: K562 cells, Primary antibody: CSB-PA703502(IL17RA Antibody) at dilution 1/200, Secondary antibody: Goat anti rabbit IgG at 1/8000 dilution, Exposure time: 1 minute
-
-
其他:
產(chǎn)品詳情
-
Uniprot No.:
-
基因名:
-
別名:CANDF5 antibody; CD217 antibody; CD217 antigen antibody; CDw217 antibody; CTLA8 antibody; HIL 17R antibody; hIL17R antibody; I17RA_HUMAN antibody; IL 17 receptor A antibody; IL 17 receptor antibody; IL 17RA antibody; IL-17 receptor A antibody; IL-17RA antibody; IL17 antibody; IL17A receptor antibody; IL17R antibody; IL17RA antibody; IMD51 antibody; Interleukin 17 receptor A antibody; Interleukin-17 receptor A antibody; MGC10262 antibody
-
宿主:Rabbit
-
反應(yīng)種屬:Human
-
免疫原:Synthetic peptide of Human IL17RA
-
免疫原種屬:Homo sapiens (Human)
-
標(biāo)記方式:Non-conjugated
-
抗體亞型:IgG
-
純化方式:Antigen affinity purification
-
濃度:It differs from different batches. Please contact us to confirm it.
-
保存緩沖液:-20°C, pH7.4 PBS, 0.05% NaN3, 40% Glycerol
-
產(chǎn)品提供形式:Liquid
-
應(yīng)用范圍:ELISA,WB,IHC
-
推薦稀釋比:
Application Recommended Dilution ELISA 1:2000-1:10000 WB 1:500-1:2000 IHC 1:100-1:300 -
Protocols:
-
儲存條件:Upon receipt, store at -20°C or -80°C. Avoid repeated freeze.
-
貨期:Basically, we can dispatch the products out in 1-3 working days after receiving your orders. Delivery time maybe differs from different purchasing way or location, please kindly consult your local distributors for specific delivery time.
-
用途:For Research Use Only. Not for use in diagnostic or therapeutic procedures.
相關(guān)產(chǎn)品
靶點詳情
-
功能:Receptor for IL17A and IL17F, major effector cytokines of innate and adaptive immune system involved in antimicrobial host defense and maintenance of tissue integrity. Receptor for IL17A. Receptor for IL17F. Binds to IL17A with higher affinity than to IL17F. Binds IL17A and IL17F homodimers as part of a heterodimeric complex with IL17RC. Also binds heterodimers formed by IL17A and IL17F as part of a heterodimeric complex with IL17RC. Cytokine binding triggers homotypic interaction of IL17RA and IL17RC chains with TRAF3IP2 adapter, leading to TRAF6-mediated activation of NF-kappa-B and MAPkinase pathways, ultimately resulting in transcriptional activation of cytokines, chemokines, antimicrobial peptides and matrix metalloproteinases, with potential strong immune inflammation. Involved in antimicrobial host defense primarily promoting neutrophil activation and recruitment at infection sites to destroy extracellular bacteria and fungi. In secondary lymphoid organs, contributes to germinal center formation by regulating the chemotactic response of B cells to CXCL12 and CXCL13, enhancing retention of B cells within the germinal centers, B cell somatic hypermutation rate and selection toward plasma cells. Plays a role in the maintenance of the integrity of epithelial barriers during homeostasis and pathogen infection. Stimulates the production of antimicrobial beta-defensins DEFB1, DEFB103A, and DEFB104A by mucosal epithelial cells, limiting the entry of microbes through the epithelial barriers. Involved in antiviral host defense through various mechanisms. Enhances immunity against West Nile virus by promoting T cell cytotoxicity. Contributes to Influenza virus clearance by driving the differentiation of B-1a B cells, providing for production of virus-specific IgM antibodies at first line of host defense. Receptor for IL17C as part of a heterodimeric complex with IL17RE.; (Microbial infection) Receptor for SARS coronavirus-2/SARS-CoV-2 virus protein ORF8, leading to IL17 pathway activation and an increased secretion of pro-inflammatory factors through activating NF-kappa-B signaling pathway.
-
基因功能參考文獻:
- The SNP rs4819554 in the promoter region of IL17RA significantly influences the response to anti-TNF drugs at week 12. PMID: 27670766
- Combination of polymorphisms in the NOD2, IL17RA, EPHA2 and KALRN genes could play a significant role in the development of sarcoidosis by maintaining a chronic pro-inflammatory status in macrophages PMID: 29554915
- The data connect increased interleukin (IL)-17A/IL-17RA signaling in autism spectrum disorder patients with enhanced oxidative inflammation in monocytes. PMID: 28935156
- IL-17RA is essential for mucocutaneous immunity to Candida and Staphylococcus, but otherwise largely redundant PMID: 27930337
- Here, we discuss the latest discoveries on the role of the IL-17A/IL-17RA axis in driving host pulmonary defence and immunopathology. PMID: 27033174
- High IL-17RA expression is associated with prostate cancer. PMID: 26871944
- Expression of these mediators was confirmed in end-stage COPD. Thus, accumulation of mast cells in COPD may contribute to vascular remodeling. PMID: 28298222
- cyanidin specifically recognizes an IL-17A binding site in the IL-17A receptor subunit (IL-17RA) and inhibits the IL-17A/IL-17RA interaction. PMID: 28223414
- SNP rs4819554 in promoter is associated with functional severity of ankylosing spondylitis PMID: 27415816
- It has been shown that IL-17 can be produced by enteroendocrine chromogranin A-positive cells as well as by goblet cells in the human colon. PMID: 27660002
- Results suggest that IL-17-IL-17R interaction in GSCs induces an autocrine/paracrine cytokine feedback loop, which may provide an important signaling component for maintenance/self-renewal of GSCs. PMID: 26755664
- High IL-17RA expression is associated with Intrahepatic Cholangiocarcinoma. PMID: 26228109
- Identified the IL17RA rs4819554 SNP as a risk factor for psoriasis. PMID: 26347322
- IL-17 receptor A and adenosine deaminase 2 deficiency due to deletion mutations was found in siblings with chronic mucocutaneous candidiasis and chronic systemic inflammation. PMID: 26607704
- In vitro, CSE stimulation significantly increased IL-17F and IL-17R in 16HBE (2.5%) and A549 (5%) while IL-17A and IL-17F in PBMC (10%). IL-17A and CSE stimulation, rather than CSE or rhIL-17A alone, increased proliferation in 16HBE and apoptosis in A549 PMID: 26198032
- The data indicate that the genetic variants of rs2275913 in IL-17A, rs763780 in IL-17F, and rs4819554 in IL-17RA may not play a role in the pathogenesis of preeclampsia in Chinese Han women. PMID: 26451724
- IL17F and IL17RA polymorphisms modulate susceptibility to cerebral malaria(CM) and provide evidence that IL-17F protects against CM. PMID: 26667835
- Increased expression of IL-17RA plays an important role in gastric cancer progression, migration and prognosis. PMID: 26261590
- Both genetic variants of IL-17R (rs882643 and rs2241049) were associated with PGD. This confirms a genetic predisposition toward PGD and suggests a role of IL-17 in driving neutrophilia in PGD. PMID: 25935436
- The presence of IL7R polymorphisms seems to be related to severe liver disease in HIV/hepatitis c virus coinfected patients. PMID: 26123260
- expression of immunoreactivity for IL-17A, IL-17RA, IL-17E, and IL-17F was significantly elevated in prostatic tissue from benign prostatic hyperplasia and prostate cancer compared with that in controls PMID: 26356122
- genetic polymorphism is associated with a reduced renal filtration rate, and with the risk of developing end stage renal disease in healthy elderly from Spain PMID: 25636567
- IL17RA polymorphisms, but not those of IL17, can influence both the development and the bilaterality of papillary thyroid carcinoma PMID: 25484349
- IL-17R was almost exclusively expressed by endothelial cells, not by myeloma cells in the masses of skeletal extramedullary disease patients. PMID: 24916639
- Interleukin-17 receptor A crystal structure shows that the downstream motif of IL-17RA SEFIR together with helix alpha C could provide a composite ligand-binding surface for recruiting Act1 during IL-17 signaling. PMID: 24816115
- IL17-dependent retinal degeneration in a mouse model of focal retinal degeneration can be prevented by gene therapy with adeno-associated virus vector encoding soluble IL17 receptor PMID: 24780906
- Whereas no association was found between the alternative splicing SNP, rs6897932, and multiple sclerosis, a significant link was found between the promoter single nucleotide polymorphism, rs11567685, and the disease. PMID: 24166352
- Genetic variation in interleukin-17 receptor A is functionally associated with chronic rejection after lung transplantation. PMID: 24263024
- Data show that the interleukin (IL)-17 receptor IL-17RA variant is generated by spliced out of exon 11 encoding the transmembrane region in a variety of tissues. PMID: 24084331
- The increased IL-25 levels in plasma and the expression of IL-17RA and IL-17RB on eosinophils in allergic asthma patients suggests that IL-25 may activate eosinophils during allergic inflammation. PMID: 24247484
- crystal structures of homodimeric IL-17A and its complex with IL-17RA, are reported. PMID: 23695682
- Il-17R SNPs were not associated with psoriatic arthritis susceptibility in northern Italians. PMID: 22955875
- polymorphism of IL-17R plays no significant role in incidence of chronic periodontitis and Periimplantitis. PMID: 23852838
- Our results might be helpful for explaining the missing heritability of the psoriasis due to epistasis and provide a deep insight into the important role of the IL23/Th17 pathway in the pathogenesis of psoriasis. PMID: 22909235
- Data suggest that the interleukin 17 receptor A (IL17RA) minor alleles of the three single nucleotide polymorphisms (SNP) may decrease the risk of Aspirin Exacerbated Respiratory Disease (AERD) via attenuation of IL17RA gene expression. PMID: 23220496
- IL-17A/IL-17RA interaction promoted the metastasis of OS in nude mice. PMID: 23192273
- Our data indicates that serum IL-17 levels are significantly increased in intractable Graves disease and affected thyrocytes show functional IL-17R expression. PMID: 23501056
- Two polymorphisms within the IL17E and IL17RA genes are associated with ESRD independent of age and sex. PMID: 23147652
- Data show that IL-17RA, IL-17RC, IL-22R1, ERK1/2 MAPK and NF-kappaB pathways are involved in Th17 cytokine-induced proliferation. PMID: 22898922
- protein levels of IL-17 and IL-17R positively correlated with the frequency of seizures in focal cortical dysplasias patients patients. PMID: 23334598
- IFN-alpha could be associated with the expansion of IL-7Ralpha(low) CD45RA(+) EM CD8(+) T cells in the CMV-uninfected elderly PMID: 22484243
- Blockage of IL-17RA with an anti-IL-17RA antibody inhibited the production of IL-6, IL-8, and MMP-3; demonstrate the functional significance of IL-17RA in psoriatic arthritis PMID: 21894442
- mRNA levels of IL-17, IL-17R and MMP-9 were also higher in the invasive group than in the non-invasive group in human pituitary adenomas. PMID: 21279695
- IL-17/IL-17RA signaling plays an important role in myocardial collagen metabolism in hypertension-induced diastolic dysfunction. PMID: 21530504
- IL-17 may have an important role in the occurrence of nasal polyps by specific combination with IL-17R and over-expression in nasal polyps. PMID: 16874957
- Human periodontal ligament fibroblasts are a target of Th17, and that IL-17 appears to up-regulate the expression of IL-23 p19 via a homeostatic mechanism involving Akt-, p38 MAPK-, and ERK 1/2-dependent NF-kappaB signalling versus the JNK/AP-1 pathway. PMID: 21145111
- an extended SEFIR domain is required for il-17RA-mediated signal transduction. PMID: 20729198
- Expression, modulation and signalling of IL-17 receptor in fibroblast-like synoviocytes of patients with rheumatoid arthritis PMID: 11966773
- cell membrane IL-17R is required for signaling by both IL-17A and IL-17F PMID: 15972674
- In this JEG-3 cell model of human trophoblast, the IL-17 receptor may have a regulatory role in trophoblast invasion. PMID: 16533341
顯示更多
收起更多
-
相關(guān)疾病:Immunodeficiency 51 (IMD51)
-
亞細胞定位:[Isoform 1]: Cell membrane; Single-pass type I membrane protein.; [Isoform 2]: Secreted.
-
組織特異性:Widely expressed.
-
數(shù)據(jù)庫鏈接:
Most popular with customers
-
YWHAB Recombinant Monoclonal Antibody
Applications: ELISA, WB, IHC, IF, FC
Species Reactivity: Human, Mouse, Rat
-
Phospho-YAP1 (S127) Recombinant Monoclonal Antibody
Applications: ELISA, WB, IHC
Species Reactivity: Human
-
-
-
-
-
-